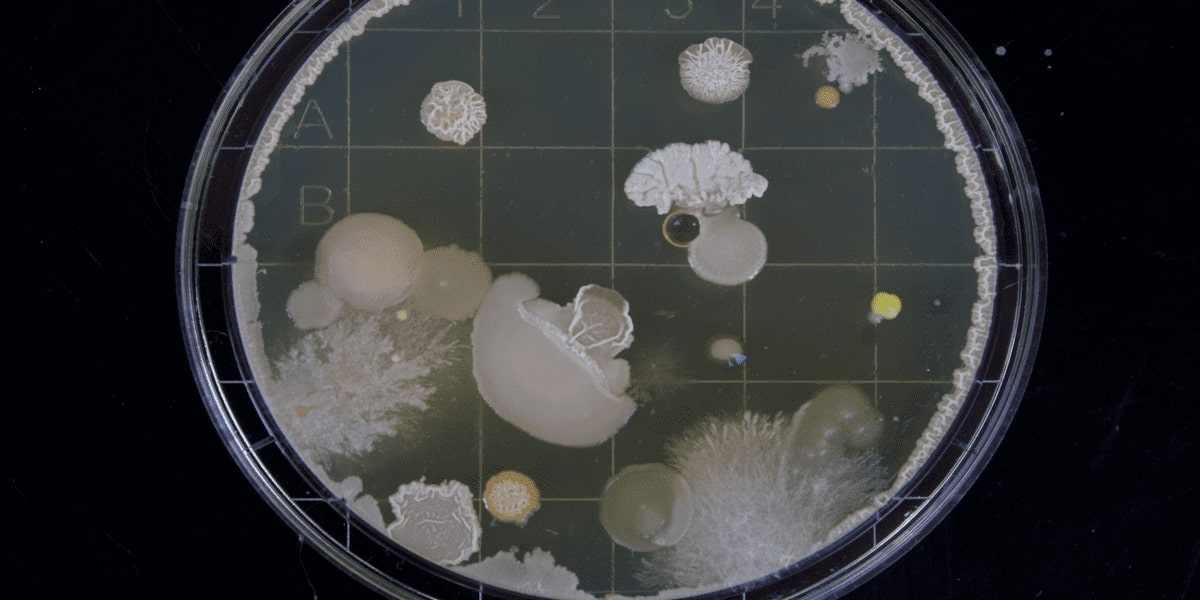
Microalgae: The Future of Protein

About Us
Premium Insights
Expert Views
Compliance
Experts
Careers
Contact Us
Our Expert Views content provides the ideal narrative for businesses, subject matter experts, and those interested in the expert network industry's latest trends and talking points. These in-depth perspectives cover various industries, business verticals, sectors, and regions, supporting our global clientele.


Team Lead- India
Protein is vital yet costly in poultry feed. Quality, amino acid balance, and source diversity determine bird health, productivity, and profitability—making careful procurement, handling, and evaluation of soy and alternatives essential.


Founder & CEO
Sumwin’s patented technology efficiently reduces 3-MCPDE and GE in palm oil using low-capex, low-OPEX solutions, including REDGEM® adsorbent and deodorizer modifications, ensuring compliance with EFSA limits without compromising throughput.


Head of New Product Development
Global overfishing and rising seafood demand are driving interest in plant-based and cultivated fish. The article explores key challenges—protein sources, texture, nutrition, cost, and consumer perception—in developing sustainable seafood alternatives.


Retail Business Area Manager
Perfect Store Execution is a structured, cross-functional FMCG process involving sales, marketing, trade, and HR to ensure optimal in-store presence, maximize new product launch impact, and extend across offline and online channels.


Team Lead- India
Eggs are a highly nutritious, affordable, and globally consumed food, providing complete protein, essential vitamins and minerals, supporting growth and health, with India offering some of the cheapest prices worldwide.

CEO
Rising population and limited resources challenge traditional food production. Microalgae-based fermentation offers a sustainable, nutrient-rich solution, using seawater and enabling immediate deployment to secure future global food supply.